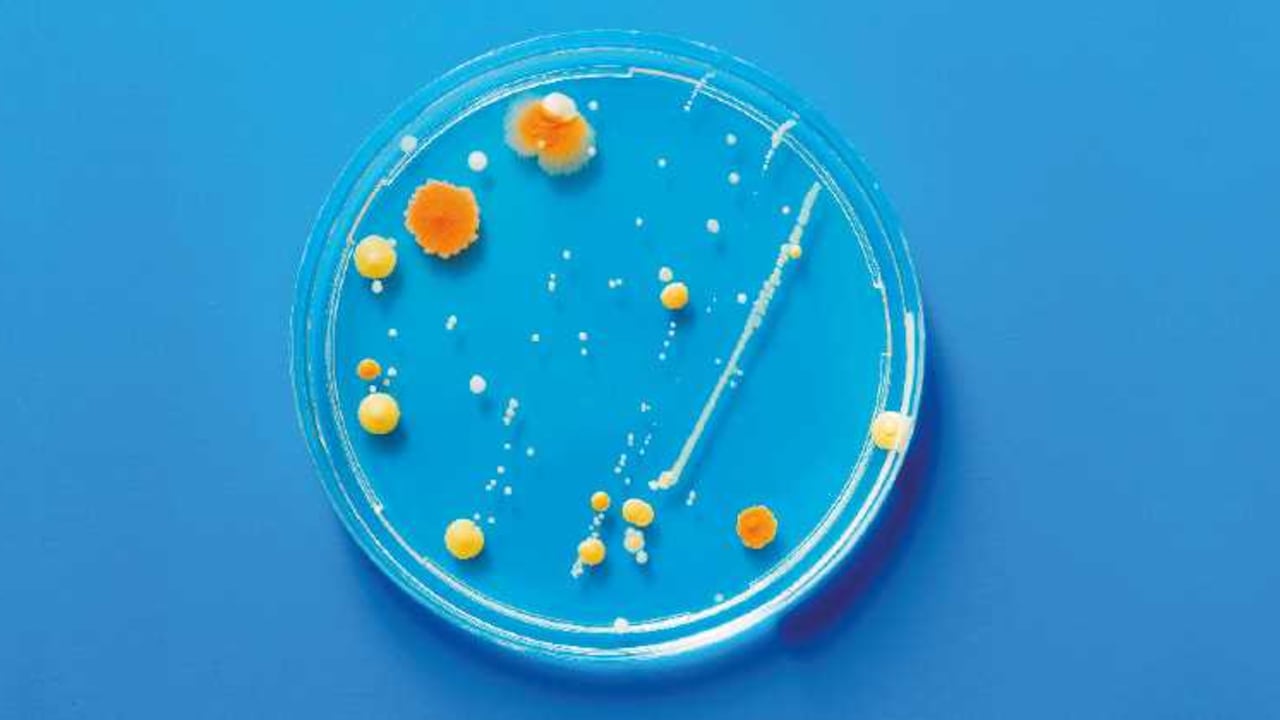

Uno de los grandes retos científicos es encontrar la causa del mal de Alzheimer. Esta semana, un grupo de investigadores de la Universidad de Harvard planteó una novedosa hipótesis que dejó pensando a más de uno. Según los expertos, pequeños microorganismos como hongos, virus o bacterias que logran llegar al sistema nervioso central harían que el cerebro genere una respuesta inmune para defenderse de la infección.
En medio del caos de esa lucha se produciría una proteína llamada amiloide, que con el tiempo se convertiría en las placas que caracterizan la enfermedad. Aunque faltan datos para confirmar la teoría, los especialistas creen que la hipótesis tiene mucha lógica y no descartan confirmarla. El estudio apareció en la revista Science Translational Medicine.